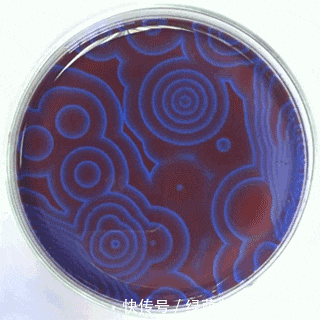
氧化|17个隐藏在生活中的魔幻化学反应

氧化|17个隐藏在生活中的魔幻化学反应
为什么有人觉得科学无趣晦涩?因为TA从没想过,也没有人告诉TA,生活中存在万千奇妙的现象,而它们都可以在科学中找到解释。
01:飞机上不能带水银的原因
文章图片
水银(金属汞)会穿透金属铝表面的一层具有保护作用的氧化膜,使铝发生快速而持续的氧化,动图中冉冉升起的物质就是铝氧化后的产物。
这就是为什么在飞机上禁止携带水银的原因,因为对于铝来说水银就像一个黑洞,飞机外壳使用的铝完全禁不住水银的进攻。
02:水银的心跳
文章图片
这个实验需要把水银浸泡在重铬酸中,并用一根铁钉接近水银表面但不碰到。重铬酸使水银(金属汞)氧化,产生一层氧化汞。水银表面的氧化汞减少了水银的表面张力,使得水银液滴变得更扁平。
变得扁平的水银表面就可以接触到远处的铁钉。水银和铁钉接触后使铁氧化,同时自己还原复又成为金属汞。重新变回金属汞后表面张力增加,水银液滴变得更圆润饱满。因此这个反应就这样反复进行,使得水银有了“心跳”。
03:斑马图案的起源
文章图片
斑马身上的图案,和一个奇特的反应——B-Z振荡反应(BZR)有关。B-Z振荡这个著名的反应是第一类被发现的化学振荡反应,它一般需要溴和一种酸作为反应物。
这个反应背后有个悲伤的故事。
B-Z振荡反应的B代表的是一个人名Belousov(别洛索夫)。20世纪50年代,前苏联化学家别洛索夫在研究人体内葡萄糖的化学反应时发现了这个振荡反应。可是,那时候的化学家普遍认为化学振荡反应是不可能发生的,他们认为化学反应就像球自然地从山上滚下来然后达到平衡一样,是不可能自发地沿着山坡上下滚来滚去的。
因此,别洛索夫的两次投稿都以“无法解释机理”及“不可能”的原因而被退了回来,无法发表在一流的学术期刊上。别洛索夫心灰意冷之下退出了科研圈。
1961年,前苏联的一个生物物理学毕业生 Zhabotinsky(扎鲍廷斯基)重新研究了这个反应,用丙二酸代替了柠檬酸,并且对这个反应的机理作了一些解释,使得B-Z振荡反应真相大白,而他的姓的首字母也被加到了这个反应的名字中。
B-Z振荡反应永远地改变了人们对科学的认识,原来化学反应不一定要保持在平衡态。更重要的是,这个反应证实了计算机之父阿兰图灵对于形态发生的猜想,解释了斑马、蜥蜴等生物身上条纹的来源——自组织而不是有序的统一控制。
04:法老之蛇
文章图片
这个酷炫诡异的实验其实也会发生在烟花中。硫氰酸汞遇热燃烧,产生蓝色的火焰和蜿蜒如蛇的固体产物。燃烧产物之一的硫化汞会接着和空气中的氧气反应,产生有毒的水银。因此不建议在家做法老之蛇实验。
05:尿不湿的秘密
文章图片
你小时候用过尿不湿吗?尿不湿吸水的秘密就在于聚丙烯酸钠。
聚丙烯酸钠是一种高分子化合物。当聚丙烯酸钠遇到水的时候就会变成固体啫喱,它可以吸收自身重量200-300倍的水分,因此具有吸附和固定水分子的功能。
06:碘钟反应
文章图片
碘钟反应(Iodine clock reaction)是一种经典的化学振荡反应。碘钟反应有许多变式,其中一个所需的原料是碘化钾、淀粉和硫代硫酸钠。
碘钟反应的本质是因为,一开始遇到淀粉能变蓝的单质碘被某个反应转化成了碘粒子,而碘粒子遇到淀粉不能显示颜色。而当这个反应所需的另一个原料被消耗完以后,这个反应立刻停止,而碘粒子得以重新形成单质碘,产生经典的碘蓝反应。
07:交通灯反应
文章图片
这个像交通灯一样变色的反应属于化学钟,和前文中的B-Z振荡反应、碘钟反应一样也属于振荡反应。
交通灯反应需要用到葡萄糖、氢氧化钠、靛蓝胭脂红和水。靛蓝胭脂红是一种酸碱度指示剂,当溶液ph值低于11.4时,靛蓝胭脂红显示蓝色,ph值高于13时显示黄色。靛蓝胭脂红同时也是氧化还原指示剂,当发生还原反应时会变成黄色。
初始时溶液是黄色的。随着烧瓶的摇晃,空气中的氧气溶解到溶液中,少量靛蓝胭脂红被溶液中溶解的氧气氧化变成红色;如果所有靛蓝胭脂红都被氧化,溶液就会变成绿色;如果将溶液静置,那么靛蓝胭脂红就会被碱性的葡萄糖溶液还原,变回黄色。这就是“交通灯”这个名字的来源。
08:燃烧的火柴
文章图片
火柴头里含有红磷、硫和氯酸钾。红磷产生的热使氯酸钾分解产生氧气。氧气进一步和硫发生化学反应,燃烧产生的短暂火焰就可以被用来点亮蜡烛了。
推荐阅读
- 又一“高层次人才”!厨师小哥被认定!新机会就藏在你家“厨房”
- 重庆|醉驾男子藏在草丛“暗中观察”,面对交警询问,一句话“露出马脚”!
- 男孩|丽江被抱走男孩获救画面公布 找到时被藏在山洞
- 玩火|《白色月光》喻恩泰玩火渣出新高度 把第三者藏在身边,还是张一好闺蜜
- 带着贝拉去旅行|世界上女性最美的17个国家,乌克兰第2韩国第3,俄罗斯让人意外!
- 117|青岛农业大学117个项目获批省级大学生创新创业训练计划项目
- 热木星|系外行星的高温大气层会产生钛雨和氧化铝云
- 进展|人工光合作用技术取得进展 阳光、二氧化碳和水能变成燃料
- Apple|隐藏在 iPhone 和 iPad 设备中的小磁铁,远比你想象中的重要
- 这个七夕,不要“孤寡孤寡孤寡”
